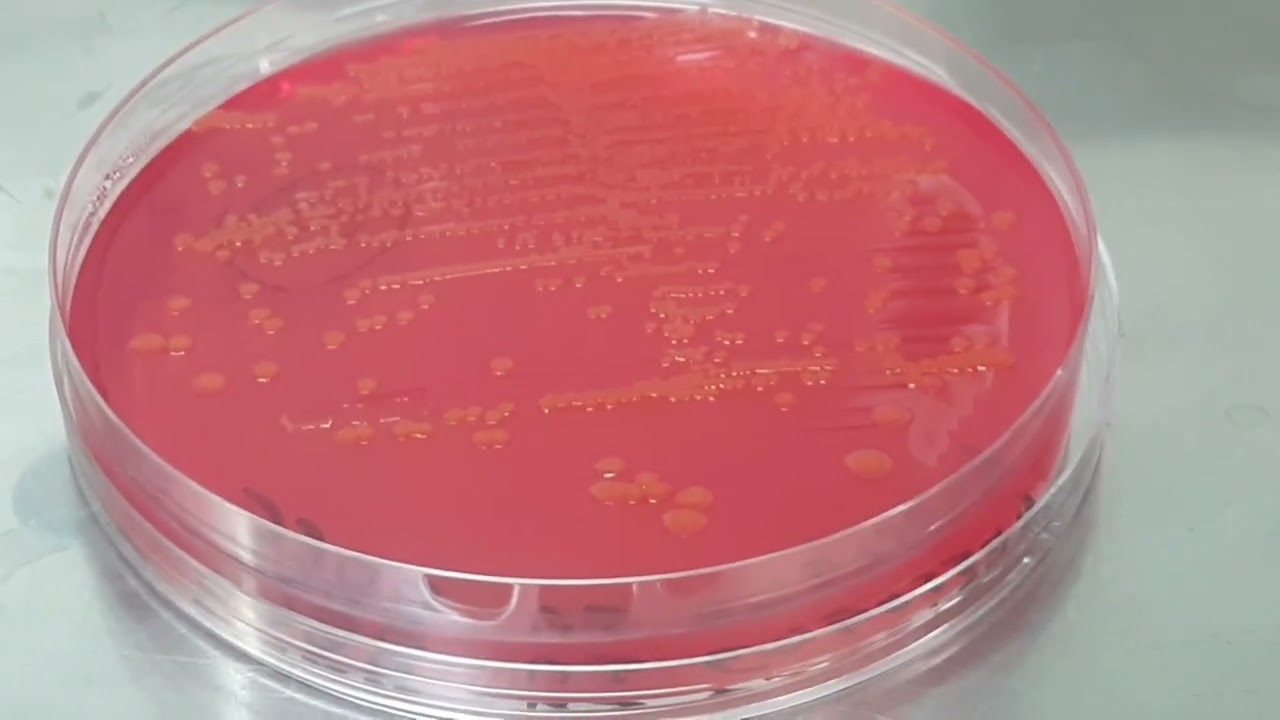

E coli 10 6
E coli 10 6 112 фото
Замочить красный лук
Экшн камеры вода
Варочная панель электролюкс ошибка е6
Втб оформление ипотеки документы
Выплаты и льготы опекунам
Банк сдать валюту
Циан квартиры мичуринск
1с предприятие язык программирования
Сочинение чему учит теплый хлеб
Майнкрафт вампиры гайд